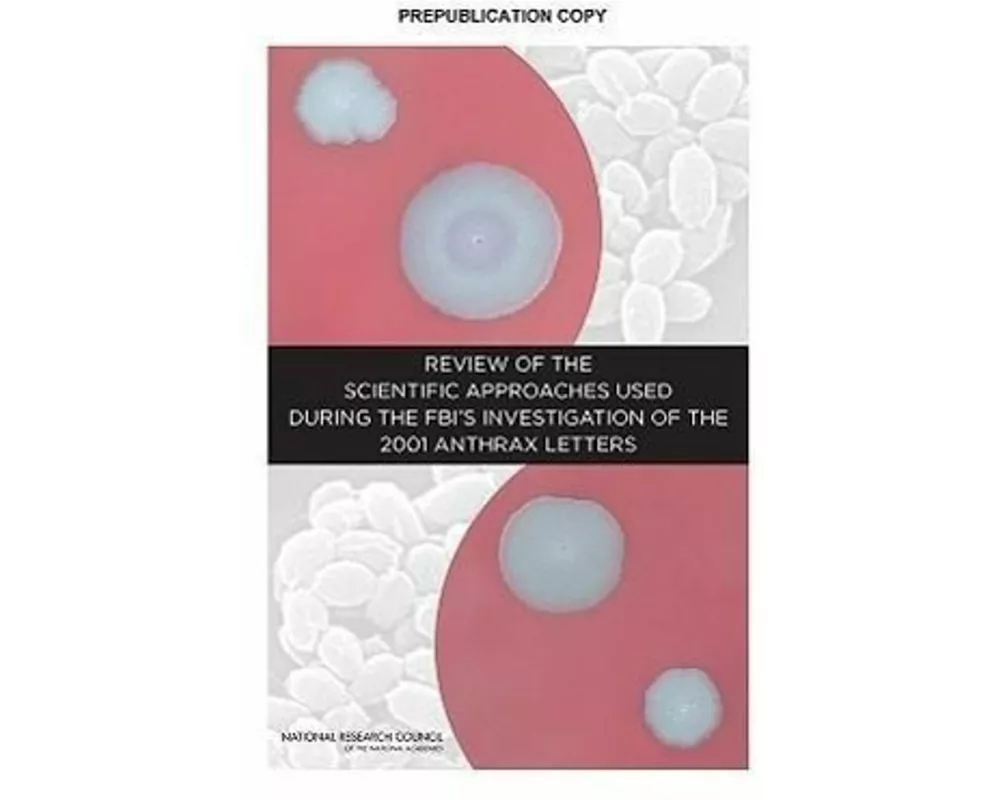
Review of the Scientific Approaches Used During the FBI's Investigation of the 2001 Anthrax Letters

Marke: National Academies Press
Hier finden Sie zu den besten Preisen alle Produkte der Marke National Academies Press.
Bestellungen bis 17:00 Uhr für Produkte auf Lager erhalten Sie - ohne Versandgebühr - am nächsten Werktag.
1
Meistgekauft
Erhältlich:
Nicht auf Lager
Achieving High Educational Standards for All
Conference Summary
-4.5 %
CHF 85.–
2
Meistgekauft
Erhältlich:
Nicht auf Lager
The Richard and Hinda Rosenthal Lectures 2005
Next Steps Toward Higher Quality Health Care
CHF 41.–
3
Meistgekauft
Erhältlich:
Nicht auf Lager
Review of the Scientific Approaches Used During the FBI's Investigation of the 2001 Anthrax Letters
-2.5 %
CHF 77.–
4
Erhältlich:
Nicht auf Lager
A Community-Based Flood Insurance Option
-14.6 %
CHF 76.–
5
Erhältlich:
Nicht auf Lager
Innovations in Health Literacy Research
Workshop Summary
CHF 65.–